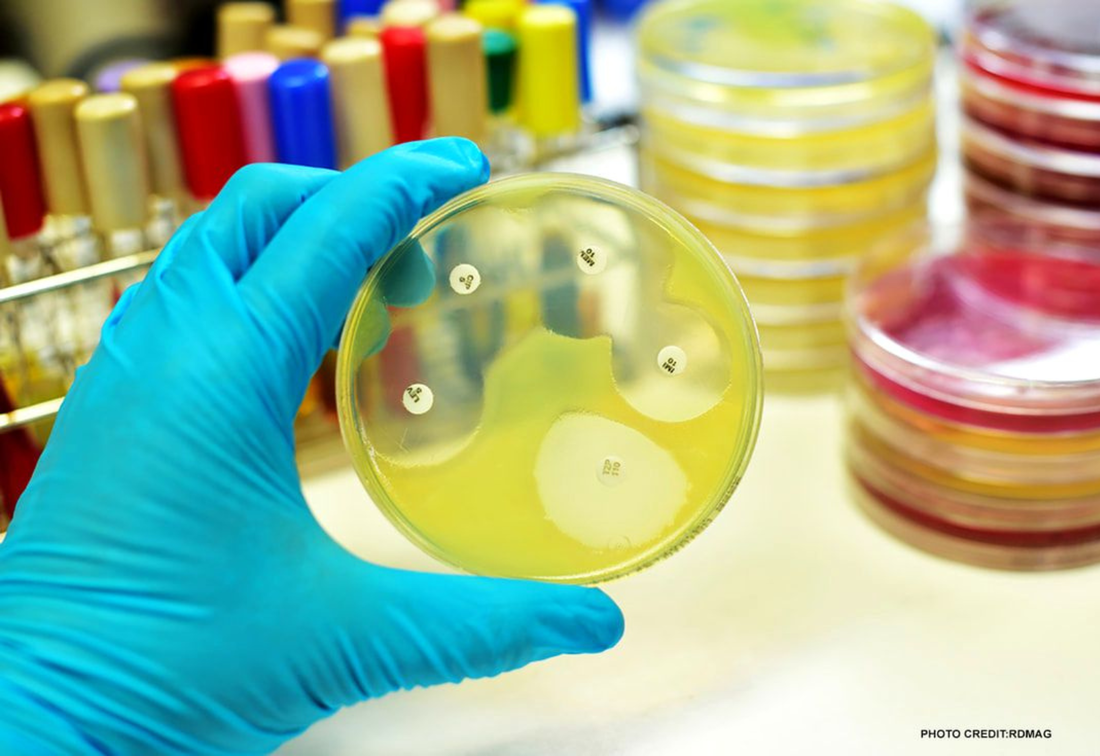
Healthcaretoday, AMR, Antimicrobial resistance, antimicrobial drugs, antibiotics, antibiotic misuse,

Do you need antibiotics for a sore-throat?Understanding the critical difference between viral and bacterial infections
|
5 Misconceptions about antibiotics you need to stop believing
The impact of antibiotic misuse on viral infections leading to bacterial resistance
|
Confronting antimicrobial resistance: A global health challenge
How is climate change fueling the rise of antimicrobial resistance?
|
Antimicrobial Resistance (AMR): The next global and public health threat after COVID-19
The adverse effects of overprescribing antibiotics
|
The bacterial threat as a result of antibiotic misuse10 million deaths from AMR projected by 2050, surpassing cancer.
|